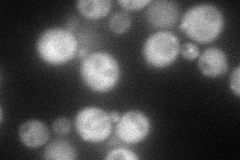
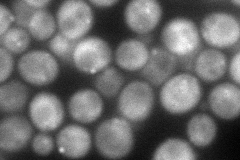
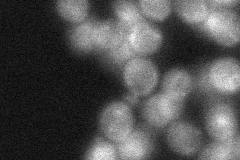

View description
Putative protein of unknown function; green fluorescent protein (GFP)-fusion protein localizes to both the cytoplasm and the nucleus
Localization:
Intensity:
Fold change:
Significance:
-
C’ GFP library in SD

cytosol36.59 -
N' NOP1pr-GFP in SD
cytosol,punctate83.5233 -
N' TEF2pr-mCherry in SD
punctate103.902 -
N' NATIVEpr-GFP in SD
cytosol32.1619 -
N' TEF2pr-VC and Cyto-VN in SD

cytosol57.7316 -
C’ GFP library in SD+DTT

cytosol27.830.76No -
C’ GFP library in SD+H2O2

cytosol33.50.91No -
C’ GFP library in Starvation Media

nucleusN/AN/AYes -
C’ GFP library on the background of Pup2-DaMP

cytosol -
C’ GFP library on the background of CCT mutant

cytosol38.15521.04244No
